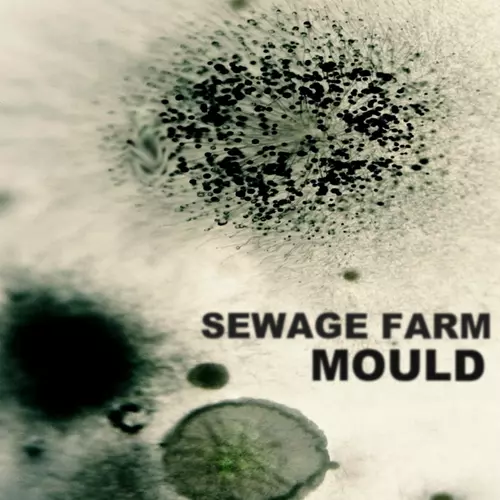
Sewage Farm - Mould

Mould
Sewage Farm
| Download EP (MP3) | 5 tracks | £4.95 | |
| Download EP (MP3) | 5 tracks | £4.95 | |
| Download EP (WAV) | 5 tracks | £4.95 | |
| Download individual tracks | From £0.99 | ||
Description
Sewage Farm - Mould
MOULD ALSO AVAILABLE AS A LIMITED EDITION GOLD CASSETTE AT SAFE SUBURBAN HOME BANDCAMP: safesuburbanhomerecords.bandcamp.com/album/mould
Mould EP is the latest release by UK garage rock band, Sewage Farm. The five-track EP was recorded by the band live at the Melrose Yard rehearsal rooms in York in June 2019. It was the last time that the band played together before the pandemic, and these tracks were later overdubbed with a harmony vocal and an extra guitar track in 2022.
Sewage Farm started in 2015 and they feature Sam Forrest (Nine Black Alps, The Sorry Kisses) on vocals and guitar, Danny Trew Barton (Cowgirl) on bass and Danny Hirst on drums. The band have released three albums but this EP is their first release for Safe Suburban Home Records. Sewage Farm have toured the UK, France, Germany and the Netherlands and have played with bands such as The Bevis Frond and Shonen Knife.
Released March 10, 2023.
Written, produced, mixed and mastered by Sewage Farm at Melrose Yard, York in June 2019.
Mould EP is the latest release by UK garage rock band, Sewage Farm. The five-track EP was recorded by the band live at the Melrose Yard rehearsal rooms in York in June 2019. It was the last time that the band played together before the pandemic, and these tracks were later overdubbed with a harmony vocal and an extra guitar track in 2022.
Sewage Farm started in 2015 and they feature Sam Forrest (Nine Black Alps, The Sorry Kisses) on vocals and guitar, Danny Trew Barton (Cowgirl) on bass and Danny Hirst on drums. The band have released three albums but this EP is their first release for Safe Suburban Home Records. Sewage Farm have toured the UK, France, Germany and the Netherlands and have played with bands such as The Bevis Frond and Shonen Knife.
Released March 10, 2023.
Written, produced, mixed and mastered by Sewage Farm at Melrose Yard, York in June 2019.
